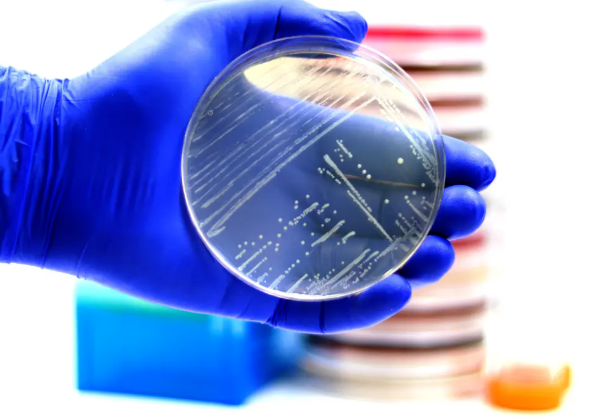

首頁
美國萬象
波及乔治亚州等!美国紧急召回近1.4万磅鸡胸肉,可能含致命细菌(美中報道)
1768915186691
美国即食鸡胸肉紧急召回!
1月16日(上周五),美国农业部(USDA)食品安全检验局(FSIS)宣布,位于乔治亚州的苏珊娜厨房(Suzanna’s Kitchen)公司召回了约13,720磅即食烤鸡胸肉片,因为该产品可能存在单核细胞增生李斯特菌(Listeria monocytogenes,简称李斯特菌)风险。

第三方实验室的检验结果显示,鸡胸肉片中李斯特菌呈阳性,这表明存在污染。FSIS表示,截至1月16日,尚未收到因食用这些鸡胸肉而导致疾病的报告。
此次召回的烤鸡胸肉片分销至阿拉巴马州、佛罗里达州、乔治亚州、密苏里州、新罕布什尔州、北卡罗来纳州和俄亥俄州,以10磅装的箱子出售,箱内含5磅装的小袋,批号为60104P13822875J14,该批号印在箱子侧面和两个包装袋上,生产日期为2025年10月14日。
消费者应立即将其丢弃或退回购买地点,如有疑问可联络Suzanna’s Kitchen客户服务总监多恩·邓肯(Dawn Duncan),信箱:dduncan@suzannaskitchen.com,也可拨打USDA肉类和家禽热线:888-674-6854,或发送电子邮件至:mphotline@usda.gov,进行咨询。
根据美国疾病控制与预防中心(CDC)统计,李斯特菌每年感染约1,600人,感染的症状因人而异,轻微症状包括发烧、肌肉酸痛、恶心、呕吐和腹泻,会持续一到三天,严重症状表现为头痛、颈部僵硬、意识混乱、失去平衡和抽搐,危及新生儿、孕妇、65岁以上的老年人和免疫系统较弱的人的生命。(168赶集)



